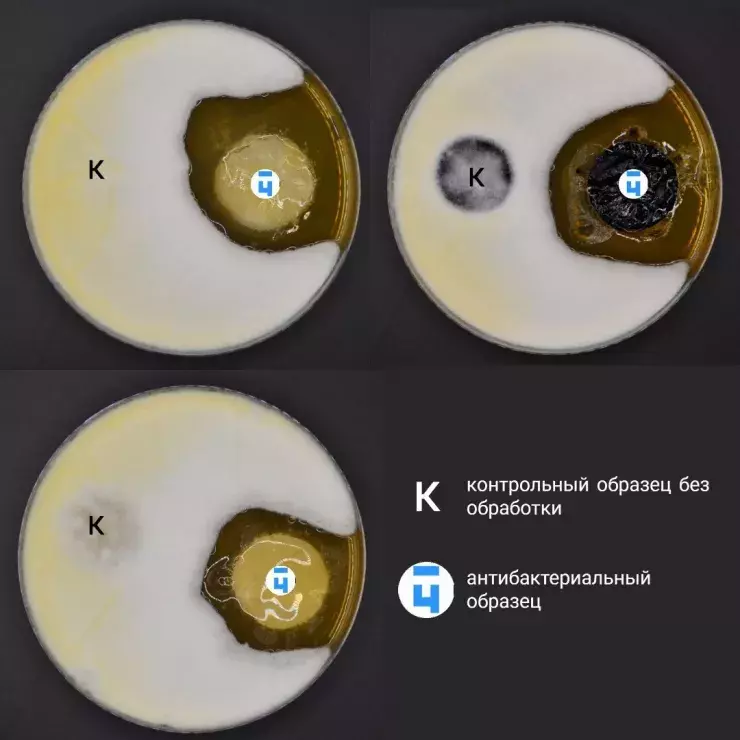
В России разработали антибактериальную упаковку продуктов

Компания «Чистая упаковка» разработала новинку, обладающую уникальными антибактериальными свойствами.
«Чистех» — это инновационная упаковка, созданная на основе уникальной биоцидной бумаги и картона, которые активно подавляют патогенные микроорганизмы, тем самым обеспечивая продление срока хранения продуктов.
Упаковочные материалы «Чистех» подавляют патогенную микрофлору, исключая появление грибков, плесени и продлевая срок хранения продуктов питания. Это позволяет сократить от 10 до 20% потери производителей и ритейлеров от порчи продукции при хранении и транспортировке.
Источник и фото: Sfera.fm